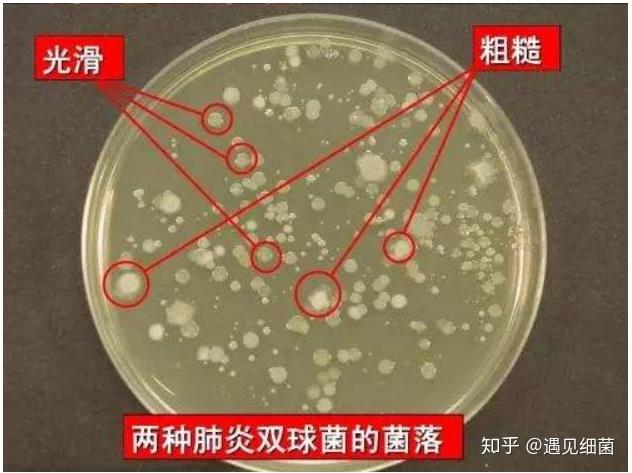
细菌与人城堡

s型细菌

瓶子里黑色的东西是什么
图片尺寸500x326
但是由于s型细菌有荚膜,能抵抗吞噬细胞的吞噬和消化,当人体免疫力
图片尺寸499x349
r型球菌与s型球菌的区别
图片尺寸640x480
为s型;若菌落表面粗糙,则为r型 (3)如图 (4)s型细菌中存在着转化因子
图片尺寸717x533
【教学参考】肺炎链球菌转化实验的9个科学问题|肺炎球菌|细菌|dna
图片尺寸641x427![质谱鉴定结果案例分析对于r-s细菌,我们首选会想到肺炎链球菌[3],笔者](https://i.ecywang.com/upload/1/img0.baidu.com/it/u=1360196816,3877460418&fm=253&fmt=auto&app=138&f=PNG?w=501&h=500)
质谱鉴定结果案例分析对于r-s细菌,我们首选会想到肺炎链球菌[3],笔者
图片尺寸693x692
细菌与人城堡
图片尺寸632x473![质谱鉴定结果案例分析对于r-s细菌,我们首选会想到肺炎链球菌[3],笔者](https://i.ecywang.com/upload/1/img2.baidu.com/it/u=944629360,3229056458&fm=253&fmt=auto&app=138&f=PNG?w=500&h=516)
质谱鉴定结果案例分析对于r-s细菌,我们首选会想到肺炎链球菌[3],笔者
图片尺寸649x670
r型菌(无,毒无荚膜 s型)菌(有,毒有膜荚)
图片尺寸1080x810
湖南省怀化市芷江一中高三生物复习课件第1节 dna是
图片尺寸1080x810
质肺双球菌炎化实转验实验材料:有 多糖胶类状膜的s型肺荚炎球双 无多
图片尺寸1080x810
艾弗里的肺炎链球菌转化实验和噬菌体侵染细菌的实验证明了dna是c.
图片尺寸860x484
下图为肺炎链球菌不同品系间的转化在r型菌转化为s型菌的过程中下列
图片尺寸486x221
单增李斯特菌的检测方法
图片尺寸380x380
是赫尔希和蔡斯的实验让世人普遍接受了dna是遗传物质吗
图片尺寸1270x751
r型细菌转化成s型细菌的关键点分析
图片尺寸750x375
乙型链球菌感染会引起多种不同致命病严重可造成链球菌败血症
图片尺寸640x480
耳道里检出的霍乱弧菌
图片尺寸660x660
杀死的s型细菌中含有某种"□10转化因子"使r型活细菌转化为s型活细菌
图片尺寸900x407
基础生物化学核酸件.pptx
图片尺寸1152x864




![质谱鉴定结果案例分析对于r-s细菌,我们首选会想到肺炎链球菌[3],笔者](https://i.ecywang.com/upload/1/img0.baidu.com/it/u=1360196816,3877460418&fm=253&fmt=auto&app=138&f=PNG?w=501&h=500)

![质谱鉴定结果案例分析对于r-s细菌,我们首选会想到肺炎链球菌[3],笔者](https://i.ecywang.com/upload/1/img2.baidu.com/it/u=944629360,3229056458&fm=253&fmt=auto&app=138&f=PNG?w=500&h=516)
















![质谱鉴定结果案例分析对于r-s细菌,我们首选会想到肺炎链球菌[3],笔者](https://studioyszimg.yxj.org.cn/AC14B126017FFE64002CFFB030ACE6E4.jpg)
![质谱鉴定结果案例分析对于r-s细菌,我们首选会想到肺炎链球菌[3],笔者](https://studioyszimg.yxj.org.cn/AC14B126017FFE63FB50BB5A79334958.jpg)











